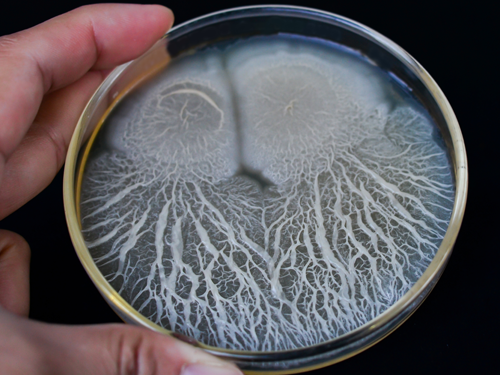

Glove Contamination Risks Exposed

Article Summary
In a groundbreaking Journal of Food Protection article*, evidence-based studies of direct physical, chemical and microbiological glove contamination affecting food and healthcare industries, consumers and patients, as well as glove wearers are discussed. It is widely assumed when gloves meet FDA compliance standards they are safe for use and free from chemical and microbial contamination. However, current glove manufacturing standards and testing requirements appear inadequate, allowing for potential contamination and public health issues.
When selecting disposable gloves, businesses face the challenge of balancing cost-effectiveness with the need for food safe performance and durability. This article discusses why verification of safe and acceptable glove performance should be a prerequisite.
Access Actionable Insights
-
White Paper | February 2025
This white paper turns research into clear, actionable guidance for food safety and procurement teams, helping reduce contamination risks and improve glove safety.
Even the most diligent programs can overlook a hidden threat: contaminated disposable gloves, the last point of contact with food.
-
Download White Paper

Article Excerpts
Ripped Gloves
“with (...) punctures in new, unused gloves that can develop into significant rips and tears, not only can direct physical food contamination occur but also chemical and microbiological contamination can find their way into food.”
Physical glove failures, such as holes and rips, are common and ongoing issues that are directly related to inexpensive raw material formulations and fillers. When a glove rips, food can be contaminated from physical glove pieces; from glove chemicals and sweat leaking onto food; and from microbial contamination from the glove wearer’s skin and from the gloves themselves.
“The extent of the liquid bridge that can emanate from a single hole a little larger than 1 μm can be deduced from the observed flow of 1.8 × 10⁴ CFU of S. aureus over a 20-min period initiated with the aid of the sweaty hand of the wearer.”

Occupational Skin Diseases (OSD)
“...gloves have been identified as sources of potentially toxic, poisonous, and deleterious chemicals that can be introduced into food, and cause dermal problems”
Gloves chemicals, which include vinyl plasticizers and nitrile accelerators, can cause skin damage, which in turn can elevate the pathogen presence on skin, including antimicrobial-resistant S. aureus. Additionally, microbial contamination found on and in gloves can affect the skin health of workers.
“OSD in the food industry is around double the average found in other industries (Ford, 2012) and represents a cluster of different types of dermatitis, each of which can have links to glove usage.”

Glove Chemical Contamination
“Direct chemical contaminants of concern include known allergens, phthalates, bisphenol A (BPA), Per- and polyfluoroalkyl substances (PFAS), and uncharacterized food contact chemicals present in gloves which may have evaded safety testing”
Hazardous glove chemicals, particularly found in vinyl gloves, are attributed to causing neurotoxicity, endocrine system disruption, carcinogenicity, fertility issues, metabolic disorders and diabetes. They migrate into foods, posing risks to consumers, with exposure also occurring through the skin, affecting the glove wearer’s health. Safety testing and regulatory oversight of these chemicals in disposable gloves are currently inadequate.
“...for most phthalates contaminating food, data suggest that a significant role is played by packaging, processing, and handling foods via gloves”

Vinyl Gloves
“...very high defect rates of new, unused gloves have been documented for vinyl and polyethylene gloves as high as 41% and 61%, respectively.”
Puncture-prone vinyl gloves are commonly used in food service because of low cost. They can put glove wearers and food products at risk due to harmful chemical migration from the glove and/or microbial contamination release if the glove tears.
“...the continued usage of phthalates in vinyl gloves may amount to several billion dollars in the US”
Glove Microbial Contamination
“Frank and opportunistic pathogens were identified on tested gloves, including recognized fecal indicators, enterotoxigenic strains of Bacillus cereus and B. anthracis along with the presence of Listeria monocytogenes, Clostridoides difficile, Staphylococcus aureus, Pseudomonas aeruginosa, and Streptococcus pneumoniae.”
Microbial contamination of gloves during manufacturing is a serious concern, with numerous pathogenic and spoilage microorganisms detected, linked to unsanitary factory conditions and polluted water sources. Those detected are of concern to food safety, healthcare-associated infections and the skin health of wearers. Appropriate bioburden standards for both healthcare and food gloves are recommended, with the detection of E. coli or S. aureus disqualifying such gloves for healthcare use.
“The presence of microorganisms identified on gloves, along with fecal indicator organisms, is suggestive of polluted water sources being utilized during manufacture.”
Solution
This peer-reviewed article exposes serious risks to food, workers and our communities. These risks need to be taken seriously, but thankfully they can be mitigated by improved glove purchasing processes.
Find out how Eagle’s traceable and ethical supply chain—including our unique proprietary Delta Zero™ glove verification testing—ensures a line of Eagle gloves meet the highest standards of glove safety and safeguard against contamination. The only gloves to be independently tested and verified in the U.S.

Improve Your Food Safety
Take 2 minutes to ensure you’re following optimal glove food safety practices and complying with regulatory and industry standards. Key recommendations will be provided, for immediate implementation.
